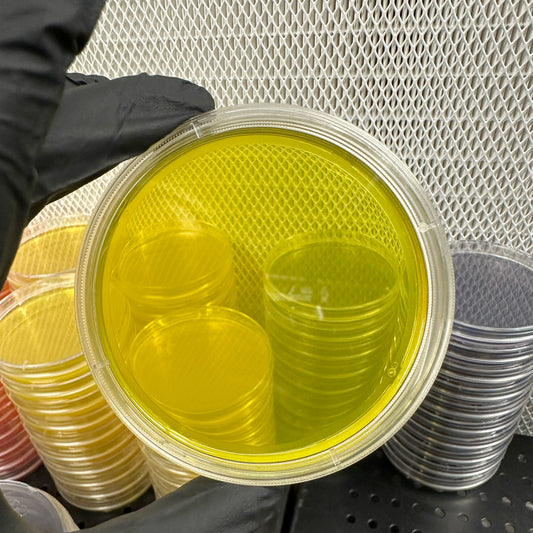
Stack of clear plastic containers with yellow interior on a metal surface.

¡NUEVO! Conjunto inclinado con rejilla
25 setas inclinadas vertidas a la medida hechas para almacenamiento a largo plazo.
Ejemplo de nombre del producto
*Puede requerirse un plazo de entrega de 5 a 10 días
Precio habitual
$19.99
Precio habitual
Precio de oferta
$19.99
Los gastos de envío se calculan en la pantalla de pago.
Cantidad
Compartir
Opciones populares de agar
-
Sorghum Yeast Agar Plates (SYA) – Pre-Poured Sterile Agar Plates
Precio habitual A partir de $7.99Precio habitualPrecio de oferta A partir de $7.99 -
Agar MYA con carbono
Precio habitual A partir de $7.99Precio habitualPrecio de oferta A partir de $7.99